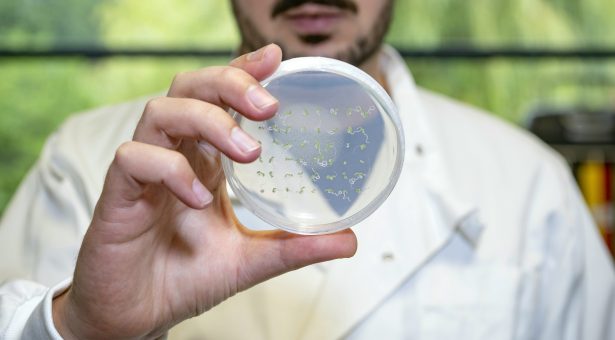

“Wow” moments in the life and career of young scientist Miguel
The past few months have been a truly memorable time in the life and career of Dr Miguel Montez. The John Innes Centre scientist achieved double success by having his research appear in two academic papers published within a few weeks of each other.
As well as these career highlights, Miguel also learned he had won a Fellowship from Wellcome, a prestigious award that opens a door to his ambition of becoming an independent group leader. And to crown it all he managed to find time to get married!
As he starts his new position (the Wellcome award started on 1 October), Miguel reflects on an amazing few weeks during the summer, outlining his hopes for the future: “I have spent a lot of time and effort building up to these achievements that it feels important to pause and reflect on them, especially since by the time you get papers published and grants awarded, you are normally already concentrating on the next stage. To have all these professional and personal milestones so closely together was a proud moment for me.”
The two academic papers in Nature Communications journal were a major source of professional pride. One study, in which Miguel is first author, concerns the detailed effect of cold on flowering time in plants; the other, dating back to his time at the Institute of Biochemistry and Biophysics (IBB, PAS) in Warsaw, investigates the effect of heat on another important process in plant development, seed germination.
“The papers are quite different in their own way but there is an underlying theme of trying to understand fundamental molecular mechanisms that enable plants to sense and respond to the environment,” he reflects. This focus has been a defining thread throughout Miguel’s research, and it remains a central theme underpinning his future work.
Miguel was a post-doctoral researcher in the group of Professor Dame Caroline Dean at the John Innes Centre, where he focused on exploring chromatin. This is the complex of DNA and proteins that forms chromosomes, the genetic information-carrying components of the cell.
As an ambitious early career researcher looking to establish a more independent group in the future, Miguel wants to fill the gaps in our knowledge about how chromatin is organised in the cell, and how it responds to the environment independently of changes to the underlying DNA sequence.
These explorations into the molecular mechanisms behind timing major developmental transitions such as flowering and seed germination are vital to our understanding of how plants survive and thrive in nature, and are very important to improve the sustainability of resources in an agricultural setting.
The applications of this fundamental research extend beyond plants because the same molecular principles that underpin a plant’s response to the arrival of spring may also be important to our understanding of how the human body senses and responds to diet, infection, or ageing.
These research questions will continue to occupy Miguel, his colleagues and collaborators as he now embarks on the £1.4m Fellowship funded by Wellcome over the next five years.
Miguel will be hosted by Professor Antony Dodd, whose group investigates how circadian rhythms adapt plants to their environment.
His Fellowship is a step in the direction towards leading a more independent research group in the future, and gives Miguel the opportunity to mentor a post-doctoral scientist who will become a central part of this innovative Wellcome-funded project.
The success of his recent papers has convinced Miguel that modern research must be multidisciplinary. The value of this approach is shown in his collaboration with the computational and molecular biophysicist Dr Rosanna Collepardo-Guevara from the University of Cambridge, which has helped to unravel the 3D structures of chromatin in response to the environment.
He explains: “The basic units of chromatin are positioned like beads on a string, and by combining data obtained in plants with Rosanna’s computational models to simulate chromatin dynamics, we were able to see how the 3D organisation of chromatin responds to cold. That was a wow moment.”
The gap in knowledge in the field of chromatin biology represents an opportunity for Miguel, an open door to use his recent success and the Wellcome funding to build his career.
Having worked in Sweden, Poland and the UK, in addition to his native Portugal, Miguel has gathered experiences and developed interpersonal skills that will serve him well in setting up his own lab one day.
“I think the key to our success in the future will be interdisciplinary; we need people who are good with computational modeling and bioinformatics, people who have expertise in biochemistry and structural biology.”
“In the future, I hope to set up a lab recruiting people from all over the world because of their skills. That is the wonderful example set by the John Innes Centre — it is a hub of diverse cultures which dynamically impacts the way we understand each other as scientists and technicians. Developing that sort of culture alongside scientific and technical skills is so important.”



